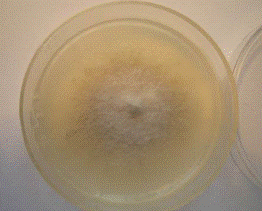

Видовой состав рода Alternaria в агроэкосистемах подсолнечника Краснодарского края
МИНИСТЕРСТВО
ОБРАЗОВАНИЯ И НАУКИ РОССИЙСКОЙ ФЕДЕРАЦИИ
Федеральное
государственное бюджетное образовательное учреждение
высшего
профессионального образования
«КУБАНСКИЙ
ГОСУДАРСТВЕННЫЙ УНИВЕРСИТЕТ»
(ФГБОУ ВПО
КубГУ)
Допустить
к защите диплома
«______»
____________________2013 г.
Заведующий
кафедрой, д-р биол. наук, проф.
Литвинская
С.А._____________________
Научный
руководитель, канд. мед.наук,
М.А.
Литвинская_____________________
Дипломная
работа
Видовой
состав рода Alternaria в агроэкосистемах подсолнечника Краснодарского края
Работу
выполнила студентка 5 курса Пономаренко Наталья Игоревна_______
Факультет
географический___________________________________________
Направление
020804.65 - «Геоэкология»_______________________________.
Нормоконтролер
доц., канд. биол. наук Пикалова Н.А.
Краснодар
2013
СОДЕРЖАНИЕ
ВВЕДЕНИЕ
. Обзор литературы
. Условия, материалы и методы
исследований
.1 Краткая характеристика
Краснодарского края
.1.1 Климат
.1.2 Рельеф
.1.3 Почвы
.1.4 Гидрографическая сеть
.2 Определение видового состава
.3 Влияние температуры и
освещенности на морфолого-культуральные свойства нескольких видов грибов рода
Alternariа, выделенных из растений и семян подсолнечника
. Результаты исследований
.1 Видовой состав грибов рода
Alternariа, поражающих подсолнечник в Краснодарском крае и симптомы поражения
растений разными видами
.2 Видовой состав грибов рода
Alternariа, выделенных из семян подсолнечника
.3 Влияние температуры и
освещенности на морфолого-культуральные свойства нескольких видов грибов рода
Alternariа, выделенных из растений и семян подсолнечника
ЗАКЛЮЧЕНИЕ
СПИСОК ИСПОЛЬЗУЕМЫХ ИСТОЧНИКОВ
ПРИЛОЖЕНИЕ 1
ПРИЛОЖЕНИЕ 2
ВВЕДЕНИЕ
Заболевания различных культурных, дикорастущих и
сорных растений, именуемые альтернариозами, известны всем фитопатологам и
работникам системы защиты растений. Причиной альтернариозов является поражение
растений микроскопическими несовершенными грибами рода Alternaria. Виды этого
рода встречаются по всему миру. Некоторые из них являются безобидными
сапротрофами, другие же, паразитические виды, вызывают вредоносные заболевания
сельскохозяйственных культур. В России экономическое значение как патогены
растений имеют около 10 видов Alternaria. В первую очередь это возбудители
альтернариозов картофеля, томатов, капусты, рапса, моркови, подсолнечника, а
также виды, связанные с заражением семян зерновых культур [Калайджян, 2003,
с.15].
Идентификация многих микромицетов и, в
частности, видов Alternaria, сопряжена с рядом трудностей, таких как сходство
морфологических характеристик разных видов и одновременно внутривидовая
вариабельность признаков. Определение видов Alternaria и мониторинг
альтернариозов осложняется номенклатурной путаницей и отсутствием полноценных
русскоязычных определительных ключей, учитывающих современную систематику рода.
В определенных случаях дополнительной трудностью
при мониторинге заболеваний и идентификация патогенов становится то, что с
одним видом растений нередко связано несколько видов Alternaria, которые могут
вызвать схожие симптомы. Несмотря на сходство проявления заболеваний,
возбудители могут значительно отличаться по патогенности, токсигенности,
степени специализации, генетике взаимоотношений с растением-хозяином,
вредоносности, чувствительности к фунгицидам и т.д. То есть, разные виды обладают
совершенно разными экологическими особенностями и хозяйственной значимостью. В
связи с этим актуальна проблема определения видового состава возбудителей
альтернариоза на территории Краснодарского края [Ганнибал, 2011, с.13].
Цель работы: определить видовой состав грибов
рода Alternaria Nees. на растениях и семенах подсолнечника в районах
Краснодарского края.
Прежде всего, передо мной стояли задачи:
выявить виды грибов рода Alternaria, поражающие
растения подсолнечника в Краснодарском крае;
выделить и идентифицировать виды грибов рода
Alternaria, поражающие семена подсолнечника в Краснодарском крае и определить
доминирующие;
установить различия по симптомам поражения
растений подсолнечника разными видами Alternaria;
Установить влияние температуры и света на
морфолого-культуральные свойства нескольких видов грибов рода Alternariа.
Данная работа составлена на 66 страницах и
состоит из введения, трех глав, заключения, списка используемых источников и
двух приложения.
1. Обзор литературы
Подсолнечник относится к обширному полиморфному
роду Helianthus, семейства астровые - Asteraceae.
Подсолнечник посевной - однолетнее растение с
прямостоячим, грубым, покрытым жесткими волосками стеблем высотой от 0,6 до 2,5
м и мощной стержневой корневой системой, проникающей в почву на глубину до 2-3
м.
Листья у подсолнечника простые черешковатые без
прилистников шершавые покрытые короткими жесткими волосками. Устьица в
эпидермисе листа расположены беспорядочно, их щели направлены в разные стороны.
На нижней стороне листа их в 1,5-2 раза больше чем в верхней. Соцветие
подсолнечника - многоцветковая корзинка, состоящая из крупного цветоложа, в
котором располагаются цветки, по краям окружена оберткой из нескольких рядов
листочков. Плод подсолнечника - семянка состоит из плодовой оболочки и
собственно семени. В плодовой оболочке заключен фитомелановый слой, защищающий
семянку от повреждения гусеницами подсолнечневой огневки (моли). Подсолнечник
имеет стержневую корневую систему. Главный корень образуется из зародышевого
корешка семени и интенсивно растет в вертикальном направлении [Васильев, 1990,
с.45].
Ареал произрастания дикорастущего однолетнего
подсолнечника охватывает сухие прерии юга и юго-запад США и севера Мексики.
Превращение подсолнечника в высокопродуктивное масличное растение происходило
также в условиях континентальногоклимата степи европейской части России. Для
климата степи характерны весенние заморозки, высокие температуры и низкая
влажность воздуха в летние месяцы, а также периодические засухи вследствие
того, что испаряемость здесь превышает количество осадков. Поэтому подсолнечник
экологически сформировался как типичное растение степной и лесостепной зон -
светолюбивое, факультативно короткодневное, приспособленное к перенесению
почвенной засухи и суховеев, сопровождающиеся высокими температурами. В то же
время подсолнечник страдает от высокой влажности воздуха, поражается грибными
болезнями в районах с морским климатом. Уровни оптимальных для формирования
урожая подсолнечника температур в значительной степени меняются с изменением
условий внешней среды. По данным исследований оптимальной была температура 25°С
независимо от условий азотного или фосфорного питания растений. Для районов
климатические условия, которых соответствуют требованиям масличного подсолнечника
к теплу и влаге, характерны в основном плодородные почвы. Известна также
широкая приспособленность подсолнечника к различным почвам. Оптимальной для
продуктивности подсолнечника является плотность черноземов 1,2-1,4г/см3.
Недостаток кислорода в почве при ее переуплотнении или затоплении подавляет
поглощение воды, рост корней и побегов, снижая продуктивность растений, причем
урожай семянок особенно сильно страдает при затоплении в фазу цветения.
Наибольшая скорость активного поглощения воды корнями подсолнечника наблюдается
при pH 5,5 почвенной среды, уменьшается она при pH 5 и 6, а подавляется при pH
4 и 8. Для подсолнечника характерна средняя степень солеустойчивости [Дьяков,
2004, с.73].
Подсолнечник отличается очень высокой
фотосинтетической активностью. По скорости ассимиляции углекислоты он
значительно превосходит многие другие виды растений.
Количество потребляемых подсолнечником элементов
питания из почвы зависит от особенностей сортов и гибридов, продолжительности
вегетационного периода и ассимиляции. Активности листьев, погодных и почвенных
условий, влагообеспеченности и плодородия почвы, а также от технологии
возделывания. Подсолнечник употребляет азот фосфор и калий на протяжении всей
вегетации подсолнечник выносит из почвы большое количество питательных веществ
- азота и фосфора в 2-3 раза, калия в 6-10 раз больше чем зерновые культуры
[Тихонов, 1988. с. 44].
Вред, причиняемый различными патогенами посевам
подсолнечника, в разной степени зависит от экологических условий.- род
микроскопических грибов, включающий множество разнообразных видов, многие из
которых распространены почти что по всему земному шару. Целый ряд видов
Alternaria вызывает вредоносные болезни сельскохозяйственных культур. Некоторые
представители рода способны становится возбудителями болезней человека и
животных, вызывать аллергию и микотоксикозы.
У грибов этого рода многоклеточные
темноокрашенные конидии с поперечными и продольными перегородками. Форма
конидий разнообразна и представляет собой вариации формы яйцевидного типа. Верхний
конец конидии вытянут в короткий или длинный «носик». У многих Alternaria
конидии образуют легко распадающиеся цепочки (рисунок 1). Однако среди
Alternaria есть представители с одиночно сидящими конидиями, у которых «носик»
обычно вытянут в длинную нить.
Конидиеносцы всегда темноокрашенные, простые или
у вершины ступенчато-изогнутые [Пидопличко, 1977, с.201].
Замедленная киносъемка процесса образования
цепочки конидий у Alternaria дала возможность отметить несколько интересных
моментов, происходящих при формировании конидии. Обычно молодая конидия
появляется на вершине конидиеносца или предыдущей конидии в виде сферического
образования. Через 10 мин после появления она начинает вытягиваться и
увеличивать свой объем. Приблизительно через 2,5 ч конидия достигает
окончательного объема. Новая конидия появляется на ее вершине только после
образования первой поперечной перегородки. Каждый раз перед образованием новой
конидии наблюдается резкое уменьшение объема уже имеющихся в цепочке спор.
Уменьшение объема идет от нижней споры к верхней. После образования конидии
объем медленно нарастает и опять резко падает перед формированием следующей
конидии в цепочке. Такие колебания объема указывают на то, что в цепочке
конидий происходит как бы «отсасывание» цитоплазмы к вершине цепочки в момент
формирования молодой конидии [Калайджян, 2003, с.43].

Рисунок 1 - Конидии Alternaria [Долженко, 2000,
с.13]
В связи с тем, что многие виды Alternaria
вызывают заболевания важных сельскохозяйственных культур, потребовалось
тщательное изучение окружающих условий, влияющих на спороношение гриба.
Оказалось, у Alternaria пасленовой (A. solani) для образования на мицелии
конидиеносцев и формирования конидий нужны разные условия. Влажность и свет являются
главными факторами, способствующими появлению конидиеносцев. Для того чтобы на
конидиеносцах стали образовываться конидии, нужны пониженная температура и
темнота. Следовательно, влияние погодных условий может ускорить или замедлить
переход гриба из одной фазы развития в другую и ускорить или замедлить
жизненный цикл патогена, т. е. повлиять на развитие болезни, вызванной
Alternaria.
Человек, зная все фазы развития патогенного
гриба и условия, способствующие прохождению этих фаз, может, воздействуя в
определенный период на гриб, повлиять на ход развития болезни. Знание всех фаз
развития гриба позволяет также предсказывать степень развития болезни в разных
климатических условиях и бороться с ней. Развитие эпифитотии зависит от
продолжительности сменяющих друг друга периодов.широко представлены в природе.
Многие из них - сапрофиты и развиваются на любых органических субстратах.
Резервуаром Alternaria являются отмирающие растения и растительные остатки, с
которых гриб попадает в почву. Наряду с другими грибами Alternaria принимает
участие в разложении и минерализации растительных остатков. Этому способствует
огромный комплекс ферментов, обнаруженный у сапрофитных альтернарий.
Богатый ферментный аппарат гриба обеспечивает
широкую амплитуду приспособленности и способность существовать в достаточно
разнообрезных условиях. Этому также благоприятствует легкое распространение
спор ветром. Споры Alternaria, иногда даже соединенные в цепочки, обнаруживают
в воздушных массах везде, где есть растения [Долженко, 2000, с.14].
Некоторые сапрофитные виды, например Alternaria
тонкая (A. tenuis), Alternaria тончайшая (A. tenuissima), Alternaria
кочаннокапустная (A. oleracea), при сильном ослаблении растений могут проявлять
паразитические свойства. Они поселяются на старых листьях, а с них переходят на
стебель и молодые листья. Это наблюдают особенно часто в случаях поражения
растения каким-нибудь другим грибом: альтернария проявляется тогда уже в
качестве вторичного паразита.
Интересно отметить, что эти же сапрофитные виды
альтернарий обычно встречаются на листьях здоровых растений в качестве
эпифитов. Там они развиты слабо, так как располагают ограниченным количеством
питательных веществ, присутствующих на листовой поверхности, и подавляются
специфическими веществами, выделяемыми растением. Можно полагать, что при
ослаблении растения они получают шанс для более интенсивного развития. Пока это
свойство эпифитных микроорганизмов недостаточно изучено, но полезные свойства
эпифитной микофлоры уже отмечены. Эпифитные организмы способны подавлять
развитие патогенов, попадающих на листья. Это установлено на примере
альтернарий.
Эпифит Alternaria тончайшая(A. tenuissima)
подавляет развитие возбудителя болезни цинний - Alternaria цинниевой (A.
zinniae). Здесь происходит не только прямое подавление прорастания спор
патогена под влиянием выделений эпифита, но, одновременно с этим, эпифит
стимулирует выделение ингибирующих веществ самого растения [Бородин, 2002,
с.42].всегда присутствуют на семенах растений. При сильном развитии гриба семя
теряет всхожесть. Во многих случаях присутствие гриба не сказывается на
дальнейшем развитии растения. Одпако грибы некоторых видов Alternaria сохраняют
и передают инфекцию с семенами, например Alternaria капустная (A. brassicae),
морковная (A. dauci), гвоздичная (A. dianthicola), цинниевая (A. zinniae) и др.
В этих случаях гриб поражает проростки либо инфекция сохраняется на корневой
шейке и обнаруживает себя в момент цветения или плодоношения, когда
устойчивость растения снижается. Если условия для развития растений
неблагоприятны, то инфекция проявляется раньше стадии зрелости растения.
Возбудитель пятнистости хлопчатника, цитрусовых и многих других культур -
Alternaria тонкая (A. tenuis) - образует тептоксин. При вымачивании семян
хлопчатника и других растений в тентоксине наблюдается сильный хлороз
проростков как результат ингибирования токсином процесса образования хлорофилла
[Семенов, 1989, с. 42].
В связи с поисками биологических методов борьбы
с болезнями растений представляет интерес Alternaria повиликовая (A.
cuscutocidae). Она вызывает побурение и гибель стеблей повилики,
распространенного паразита многих культурных растений. Из-за тесного контакта
повилики с растением-хозяином трудно применять химические методы борьбы.
Опрыскивание люцерновой повилики спорами Alternaria в Киргизии дало
положительные результаты.
В настоящее время известно более 100 видов
альтернарий, из них только около 25 наиболее широко распространены и имеют
практическое значение.
Alternaria пасленовая (A. solani)
поражает картофель и томаты. Болезнь возникает в период бутонизации и приводит
к преждевременной гибели ботвы. На листьях появляются концентрические сухие
пятна со спороношением гриба. Гриб поражает плоды
<#"664097.files/image002.gif">
Рисунок 2 - Alternaria на капусте
[Володичев, 1990, с.92]
гриб подсолнечник
alternariа краснодарский
Симптомы аллергии на этот грибок чаще всего
проявляются в конце весны и осенью [Володичев, 1990, с.93].
Виды рода Alternaria считаются возбудителями
чёрного зародыша ячменя. Заболевания, проявляющегося в виде потемнения оболочки
зерновки около зародыша. Но также часто они встречаются в бессимптомных
семенах. Виды Alternaria имеют оливковые простые, реже ветвящиеся первичные
конидиеносцы,
Среди экономически значимых заболеваний
подсолнечника не последнее место занимают альтернариозы. Это ряд заболеваний,
вызываемых несколькими видами грибов рода Alternaria, поражающих разные органы
растения (листья, корзинки и семена) (рисунок 3). Эти заболевания встречаются
везде, где возделывается подсолнечник. Вредоносность альтернариоза листьев
проявляется в уменьшении фотосинтетической поверхности листьев и снижении
количества и качества урожая. Заражая семена, грибы рода Alternaria загрязняют
их фито- и микотоксинами [Гусева, 1990, с.113].

Рисунок 3 - Листья подсолнечника, пораженные
Alternaria [Фото автора, 2012]
Род Alternaria Nees представлен более чем 250
разнообразными видами, многие из которых - космополиты, встречающиеся
практически повсеместно [Simmons, 2007, с. 451].
Они относятся к микроскопическим грибам, с
которыми человек сталкивается наиболее часто. Некоторые виды относятся
коппортунистическим, то есть способным вызывать болезни человека и животных
(аллергии, дерматиты, микотоксикозы). Эти грибы были выявлены на большом
количестве разнородных субстратов, в том числе и растительного происхождения.
Часть видов - сапротрофы, но большинство - паразиты с некротрофным способом
питания и различной специализацией и степенью паразитизма (от факультативных
паразитов до факультативных сапротрофов). Некоторые мелкоспоровые виды
(например, A. tenuissima и комплекса A. alternata) имеют большое количество
растений-хозяев, хотя несколько родственных им видов специализированы очень
узко, что связано со способностью синтезировать специфичные к хозяину токсины.
Остальные же (не мелкоспоровые) виды преимущественно приурочены к одному или
нескольким видам растений одного рода, реже нескольких родов, но одного
семейства. Целый ряд видов Alternaria вызывает вредоносные болезни
сельскохозяйственных культур, в том числе и подсолнечника.
Источник первичной инфекции - поражённые листья,
сохраняющиеся в посевном материале и в поле. Зимует гриб в виде мицелия и
конидий на заражённых остатках подсолнечника, где инфекция передаётся семенами
[Patel, 2010, с.97].
В условиях естественной эпифитологии первые
признаки болезни появляются в период налива семян, обычно через 25 дней после
конца цветения. На расширенной оси соцветия и на тыльной стороне корзинки
возникает бурое, быстро разрастающееся пятно, которое в дальнейшем охватывает
кольцом ось соцветия и часть корзинки. В местах поражения образуется обильное
спороношение гриба - темно-оливковый бархатный налет. Зачастую болезнь
проявляется в виде отдельных бурых пятен на тыльной стороне корзинки, которые
быстро разрастаются, поражая в первую очередь листья обертки. Гриб проникает
внутрь корзинки, вызывая покоричневение тканей. Подача питательных веществ к
семенам прекращается, семена остаются недоразвитыми и щуплыми. В условиях
повышенной влажности семена также покрываются бархатистой темной грибницей.
Заболевание появляется на подсолнечнике, начиная
от прорастания семян и до уборки на всех надземных органах растения. Наиболее
характерные симптомы отмечаются на листьях, которые на начальной стадии
заражения имеют небольшие светло-желтого или светло-коричневого цвета пятна
(диаметром 1 мм), часто окруженные хлоротичным ореолом. Эти пятна разрастаются
в более крупные участки поражений с неровными краями, диаметром до 4-6 мм,
имеющими по 4-5 концентрических колец. При благоприятных условиях эти участки
поражений распространяются по краям листовой пластинки к срединной части места
и в результате остается только по 1-2 мм неповрежденной ткани по обеим сторонам
основных жилок.
Со временем пятна становятся темно-коричневыми,
а затем приобретают черный цвет. Пораженные листья опадают.
На стебле появляются коричневые разнообразной
формы (чаще штриховатые) пятна. А в период цветения и налива семян болезнь
захватывает и корзину. На расширенной оси соцветия и на тыльной стороне
корзинки возникает бурое, быстро распространяющееся пятно. В местах поражения
образуется спороношение гриба - темно-оливковый бархатистый налет. Часто
болезнь бывает выражена на тыльной стороне корзинки в виде отдельных бурых
пятен, которые быстро распространяются, поражая в первую очередь листья
обертки.
Благоприятными условиями для заражения
подсолнечника патогенами являются продолжительная влажная погода и температура
воздуха от 15 до 30°С. Максимальное поражение подсолнечника возбудителем A.
helianthi происходит при температуре 25-27°С. При непрерывной влажной погоде в
течение трех-четырех суток. Инкубационный период 5-7 дней.
Альтернариоз вызывает преждевременное усыхание
подсолнечника, что приводит к ощутимым потерям урожая. Защитные мероприятия:
предпосевное протравливание семян фунгицидами, использование менее
восприимчивых сортов и гибридов, размещение подсолнечника в севообороте
[Лукомец, 2011, с.87].
Анализ публикаций, как отечественных, так и
зарубежных авторов по альтернариозу подсолнечника выявил множество противоречий
и неясностей, несмотря на то, что было проведено большое количество
исследований, касающихся симптоматики, вредоносности, экологических факторов,
влияющих на развитие и распространение болезни, методов ее контроля и т.д.
Основная проблема заключается в недостаточной изученности самого патогена.
Видовой состав грибов рода Alternaria, заселяющих растения и семена
подсолнечника, изучен мало.
До сих пор в ряде работ используются устаревшие
определители и методы идентификации, присваиваются нелегитимные наименования
видов Alternaria. Любой из так называемых мелкоспоровых видов (с конидиями
размером до 60 мкм, образующими цепочки) могут обозначать как A. alternata,
A.tenuis, A. helianthii или A. helianthi. При этом, по определителю E. G.
Simmons (2007), A. helianthi - узкоспециализированный вид с конидиями, по форме
близкими к цилиндрической, без нитевидного апикального выроста, размером до
80-130(160) х 18-23(30) мкм [Ганнибал, 2010, с.14-15].. helianthi встречается в
большинстве регионов, возделывающих подсолнечник, и продолжает распространяться
на новые территории. Так, патоген обнаружен впервые в штате Луизиана США только
в 2009 году, в Сингапуре - в 2010 году. Наибольший ущерб он наносит при
сочетании высоких температур и влажности воздуха свыше 70% . В Индии, Бразилии,
Аргентине и ряде других стран с тропическим и субтропическим климатом
альтернариоз - одна из острейших проблем при возделывании культуры. Потери
урожая семян могут доходить до 60-90%, их масличности и всхожести - до 32%.
Столь высокая вредоносность обусловила интенсивное изучение A. helianthi в
разных странах [Cho, 2011, с.506].
Среди мелкоспоровых токсигенных видов Alternaria
в разных странах мира чаще всего встречаются A. tenuissima, A. arborescens и A.
alternata. Эти три вида превалировали в США на листьях фисташки, в ЮАР на
яблоках в Северной Европе в семенах злаков и в России на растениях различных
семейств, причем чаще других встречался A. tenuissima. Как возбудители
пятнистости подсолнечника мелкоспоровые виды (упомянутые как A. alternata) были
обнаружены во многих странах Европы, Азии и Южной Америки. Перечисленные
мелкоспоровые виды являются филогенетически очень близкими, обладают
значительным морфологическим сходством и отличаются лишь типом цепочек спор.
Все они способны к синтезу нескольких микотоксинов.
Первая работа с использованием современных
систематических положений и методов идентификации, направленная на выявление
видового состава Alternaria на подсолнечнике в регионах Российской Федерации,
была выполнена Ф. Б. Ганнибалом.
Им проведена очень серьезная ревизия доступной
информации по данной теме и сделано заключение, что в настоящее время помимо
космополитных полусапротрофных, систематиками и флористами описано не менее 11
видов Alternaria, ассоциированных с подсолнечником (по определителю E. G.
Simmons (2007)).
Были проанализированы образцы пораженных частей
растений и семян подсолнечника из нескольких регионов России, в том числе и из
Краснодарского края.
В результате идентифицировано несколько видов с
абсолютно разными экологическими свойствами (органотропной специализацией,
патогенностью, токсигенностью, требованиями к освещенности и т.д.).
Также A. helianthiinficiens выявлен в Венгрии и
США, Сербии, Южной Корее, Хорватии. Список таких стран будет, безусловно,
пополняться, так как этот патоген способен инфицировать семена, а значит,
быстрее сможет распространяться на новые территории. Информации о свойствах
гриба мало. Проведенные немногочисленные исследования показали высокую
патогенность и потенциальную вредоносность A. helianthiinficiens для
подсолнечника (рисунок 4). Считают, что он может быть более патогенным для
подсолнечника, чем A. helianthi [Prasad, 2011, с.338].
Среди мелкоспоровых токсигенных видов,
выделенных Ф. Б. Ганнибалом, преобладал A. tenuissima, выделялись также A.
alternate Keissl и A. arborescens.
Многие образцы листьев и семян содержали грибы,
отнесенные к комплексу A. infectoria - преимущественно в основном
нетоксигенные, слабо патогенные виды.

Рисунок 4 - А. helianthificiens [Ганнибал, 2011,
с.17]
Впервые в России был обнаружен
специализированный к подсолнечнику вид A. helianthiinficiens (рисунок 5)
[Ганнибал, 2011, с. 15].

Рисунок 5 - А. helianthificiens на стебле
[Ганнибал, 2011, с.17]
Считается, что неспециализированные
мелкоспоровые виды A. tenuissima, A. alternata - полупаразиты, поражающие
обычно физиологически старые или поврежденные ткани. Но при определенных
погодных условиях они способны вызывать массовое заражение и быть
вредоносносными на различных однолетних культурах (картофель, томат, рапс,
подсолнечник и др.). В результате уменьшается фотосинтетическая поверхность
листьев, плесневеют плоды и семена, урожай снижается и загрязняется
микотоксинами и аллергенами [Dehpour, 2007, с.68].
Опасность повреждения масличных семян грибной
микрофлорой не исчерпывается только разрушением липидно-белкового комплекса и
снижение качественного показателя масла. В процессе микробиологической порчи
накапливаются метаболиты, многие из которых высокотоксичны для человека и
высших животных.
По результатам исследований, причиной
определяющей максимально высокие кислотные числа патогеном были грибы рода
Alternaria [Пикалова, 2009, с.32].
Эти активные микроорганизмы с высокой
адаптационной способностью продолжают бесконтрольно размножаться и
эволюционировать, осваивая новые ниши и субстраты, занимая места других
патогенов, борьба с которыми успешна, увеличивать потенциал патогенности. Все
это диктует необходимость всестороннего изучения грибов рода Alternaria и
других темноокрашенных гифомицетов, ассоциированных с подсолнечником.
2. Условия, материалы и
методы исследования
.1 Краткая
характеристика Краснодарского края
Административный центр Краснодарского края - г.
Краснодар (площадь 840 км 2, население 752,9 тыс. чел., что составляет 14,9 %
всего населения края).
В составе края - 38 районов, 15 городов краевого
и 11 городов районного подчинения, 22 поселка городского типа, 388 сельских
административных округов, объединяющих 1716 сельских населенных пунктов.
Границы края имеют протяженность 1540 км, из них морские - около 740 км.
Краснодарский край имеет государственную границу с Грузией и Украиной.
2.1.1 Климат
Климат Краснодарского края формируется под
воздействием воздушных масс приходящих с не замерзающих Черного и Азовского
морей, отличается большим разнообразием - от холодного климата высокогорий к
умеренно-континентальному климату Прикубанской низменности и лесных предгорий -
до субтропического климата Черноморского побережья Кавказа. Температура воздуха
имеет резко выраженный годовой ход, среднегодовая температура в городе
Краснодаре составляет 10,8°С. Годовое количество осадков колеблется в
значительных пределах: от 350 мм на Таманском полуострове, 500 мм на
правобережье Кубани, до 2500 мм и выше на юго-западных склонах Большого
Кавказского хребта. Преобладающими ветрами являются восточные, в весенне-летний
период носящие суховейный характер. В отдельные годы их усиление приводит к
возникновению катастрофических пыльных («черных») бурь на равнинной территории
края, а особо сильные ветры северной составляющей приводят к появлению так
называемой «боры» в районе города Новороссийска. В свою очередь, сильные и
устойчивые ветры западного направления способствуют катастрофическим нагонным наводнениям
морских вод на восточном побережье Азовского моря. В летний период, как
правило, увеличивается повторяемость западных влагонесущих потоков, особенно
сильно увеличивающих количество осадков на юго-западных склонах Кавказского
хребта и на Черноморском побережье.
На территории края находится самый теплый район
России - черноморское побережье, по климату приближающееся к субтропикам.
Главный Кавказский хребет, препятствует проникновению сюда холодного воздуха с
севера, что позволяет воде в Черном море оставаться теплой на протяжении
большей части года. Средняя температура в этом регионе зимой в январе
колеблется от - -2-5 до + 10°С, что в значительной степени определяет
благоприятный климат. Летом и осеню, вплоть до середины октября, температура
воды в море держится на уровне + 22-25°С, а воздуха + 25- 35°С.
Периодические теплые летние дожди не бывают
продолжительными. Они поддерживают постоянную влажность субтропиков, что в свою
очередь инициирует активное произрастание буйной растительности (цитрусовых
деревьев, кипарисов, пальм и тиса)
2.1.2 Рельеф
Рельеф Краснодарского края - разнообразный.
Северная и центральная части Краснодарского края - свыше 2/3 всей поверхности,
занимает Кубанская равнина, неразрывно связанная по своему рельефу и природе с
южной частью Русской равнины.
К югу от Кубанской равнины располагается другая
часть Краснодарского края, занимающая менее 1/3 его поверхности, входящая почти
полностью в горную систему Большого Кавказа.
На восточной границе края расположен западный
склон Ставропольской возвышенности, которая не относится к системе Большого
Кавказа. На западной границе края находится Таманский полуостров, который
нельзя полностью отнести ни к горной, ни к равнинной части края.
Сама Кубанская равнина не является однородной в
своих различных частях. В ее состав входят: Кубанско-Приазовская низменность,
Приазовская дельтовая низменность, Прикубанская наклонная равнина.
Кубано-Приазовская низменность расположена к
северу от Кубани и занимает наибольшую часть пространства Кубанской равнины.
Водораздельные пространства этой низменности сложены лессовидными суглинками -
наносами древних рек и древних водоледниковых потоков (древнеаллювиальными и
флювиогляциальными отложениями). Низменность наклонена в основном к
северо-западу - в сторону Азовского моря, но у границы с Ростовской областью
имеются уклоны к северу, о чем свидетельствует течение реки Большой Эльбузд,
впадающей в реку Кагальник. На границе со Ставропольским краем низменность
наклонена к востоку, о чем говорит течение реки Калалы, впадающей в реку
Егорлык.
Характер поверхности Кубано-Приазовской
низменности не везде одинаков. В пределах Ейского полуострова рельеф плоский,
речной сток отсутствует, высота над уровнем моря 10-20 метров.
В своей центральной части Кубано-Приазовская низменность
расчленена долинами рек и имеет слабоволнистый рельеф. В восточной части
низменности высоты над уровнем моря достигают 100-200 метров. Здесь
значительное количество балок и долин небольших рек, главным образом верховья
степных рек.
Приазовская дельтовая низменность располагается
в дельтах рек Кубани, Кирпили, Бейсуга, Челбаса; сложена дельтовыми
отложениями, высота над уровнем моря 0-20 м. Рельеф плоский. Прибрежные части
дельт, как правило, заболочены. Значительная часть заболоченных участков в
настоящее время осушена или осушается. Те части дельт которые расположены на
незначительном расстоянии от моря и высохли естественным путем, трудно
различимы от прилегающей равнины.
Приазовская дельтовая низменность отличается от
Азово-Прикубанской низменности не только своей высотой и плоским рельефом, но
также своеобразными формами залегания подпочвенных песчаных и глинистых
отложений.
Прикубанская наклонная равнина расположена между
долиной Кубани на севере, и горами - на юге.
В долине Кубани на значительном расстоянии
протянулись Закубанские плавни, к югу от которых равнина постепенно повышается,
достигая 250-300 м над уровнем моря.
Равнина сложена разнообразными отложениями,
главным образом речного происхождения: галечниками, песками, глинами, прикрытыми
сверху лессовидными суглинками.
К территории Краснодарского края относится
юго-западная часть Ставропольской возвышенности, достигающая 623 м над уровнем
моря (в пределах Ставропольского края - свыше 800 м).
Ставропольская возвышенность - это в общем пологое,
глыбовое поднятие. Южный крутой склон возвышенности, прорезанный оврагами и
балками, издали производит впечатление горного хребта.
Таманский полуостров представляет собой
сочетание ровных, платообразных участков с грядами и холмами - сопками, достигающими
164 м. над уровнем моря. Сопки молодые, округлой или эллипсовидной формы-
антиклинали сложены морскими отложениями палеогена, в понижениях между сопками
встречаются еще более молодые морские отложения. Большинство сопок в недавнее
время извергали, а некоторые продолжают извергать и сейчас холодную грязь
(сопочную брекчию) сложного химического состава. Встречаются выходы нефти и
метана (горючего газа) [Коробкин, 2010, с.51].
2.1.3 Почвы
Основную часть почвенного покрова степной зоны
края составляют предкавказские карбонатные и выщелоченные чернозёмы. Таманский
полуостров занят каштановыми, западно-предкавказскими и болотными почвами. В
горах - горно-лесные бурые и дерново-карбонатные почвы, в высокогорье -
горно-луговые.
Общая земельная площадь Краснодарского края
составляет 7,5 миллионов гектаров, из них пашни - 3,9 млн га. Это основной
пахотный фонд края, отличающийся высоким плодородием. Основная площадь пашни
располагается на высококачественных черноземах: карбонатных. Слабо-выщелоченных
и слитых. Производство сельскохозяйственной продукции в значительной мере
связывается с содержанием в почве гумуса.
2.1.4 Гидрографическая
сеть
Главная река Краснодарского края - Кубань,
принимающая слева много притоков (Уруп, Лаба, Белая и др.), для регулирования стока
которой сооружено Краснодарское водохранилище. Её именем часто именуют и весь
край, называя его просто Кубань. Реки бассейна Азовского моря имеют равнинный
характер, наибольшие из них - Ея, Бейсуг, Кирпили. Реки Черноморского побережья
невелики, наибольшая из них - Мзымта.
На территории края расположено много мелких
карстовых озёр, на Таманском полуострове и побережье Азовского моря -
озёра-лиманы. На территории Краснодарского края находится самое большое озеро
Северного Кавказа - Абрау. [Никитин, 2007, с.43].
2.2 Определение
видового состава альтернариозов
Идентификация возбудителей альтернариозов в
большинстве случаев начинается с визуального анализа симптомов заболевания:
бурые округлые или угловатые пятна без зональности.
Перед помещением во влажную камеру поверхность
растительного материала промывают дистиллированной водой. Материал можно
помещать непосредственно на фильтровальную бумагу либо на какие-либо подставки.
Влажные камеры выдерживаются при 20-25°С. Анализ спороношения рекомендуется проводить
с использованием бинокуляра раз в сутки до появления обильного спороношения
возбудителя болезни. Виды Alternaria обычно формируют конидии во влажной камере
через 2-5 суток инкубирования. После обнаружения конидий под бинокуляром,
приготавливают микропрепарат, который просматривают под микроскопом (рисунок
6).
Перед изоляцией грибов в чистую культуру
проводят стерилизацию поверхности изучаемого образца (семена, фрагменты
листьев, корней и т.п.) одним из стандартных методов с применением различных
антисептических веществ: 0,1% водный раствор нитрата серебра, 96% этанол, 1%
раствор марганцовокислотного калия, 1% раствор гипохлорита натрия и т.д. Затем
растительный материал раскладывает в чашки Петри с картофельно-морковным (КМА)
агаром и инкубируют при комнатной температуре.
Спороношение разных видов Alternaria при
изоляции описанными выше способами формируется через 3-10 суток. Его появление
можно наблюдая чашки Петри под микроскопом. Отсев изолятов удобно осуществлять
путем переноса стерильной иглой отдельных конидий или нескольких конидий из
одной цепочки в чашки Петри с КМА.
Состав питательной среды является наиболее
важным моментом в методике идентификации видов Alternaria. Чаще всего для
получения типичного спороношения используются 2 среды: КМА и V-8. Мы используем
КМА.

Рисунок 6 -Определитель Симмонса [Ганнибал,
2011, с.3]
Для идентификационных целей подходит температура
в пределах 20-25°С. Снижение температуры культивирования может приводить к
снижению интенсивности спороношения и образованию более крупных конидий. Более
высокая температура также ингибирует спороношение (рисунок 7).
Для нормального роста и спороношения грибов
необходимо использование питательной среды с pH 6-7. Кислотность стандартных
питательных сред обычно находится в указанном диапазоне, поэтому чаще всего
этот параметр не фиксируют. Отклонение pH среды от нормальной может оказывать
заметное влияние на культурально-морфологические свойства видов Alternaria:на
скорость роста, текстуру и цвет колоний [Ганнибал, 2011, с.18].

Рисунок 7 - 14-дневные конидии A. helianthi на
питательной среде КМА [Фото Ивебор М.В., 2012]
2.3 Влияние температуры
и освещенности на морфолого-культуральные свойства нескольких видов грибов рода
Alternariа, выделенных из растений и семян подсолнечника
В качестве объектов исследования были выбраны 3
штамма видов, выделенные из подсолнечника из Краснодарского края в 2012 году:
и 2 - A. helianthi - наиболее распространенный
специализированный вид;
- A. tenuissima - наиболее распространенный на
семенах и среди мелкоспоровых - на вегетирующих растениях подсолнечника вид.
В данном опыте проверены 2 температуры:
+ 28°С - в диапазоне оптимальной для роста и
развития данных грибов
+ 15,5°С - выбрана, так как она бывает часто в
период появления всходов подсолнечника. A. helianthi - одно из первых болезней,
что появляется на подсолнечнике, часто бывает уже на семядольных листьях.
Освещенность - считается важным фактором для
этих темноокрашенных грибов.
Изучаемый гриб высевали уколом в центр
поверхности плотной питательной среды КМА в чашках Петри диаметром 90 мм с
одинаковым слоем среды в 3 повторностях для каждого варианта (всего 4
варианта).
Культивировали при + 15,5°С и + 28°С, в условиях
полной темноты (варианты «темнота») и при 12-часовом фотопериоде (варианты
«свет»). Ежедневного достижения ими размера 90 мм либо до прекращения роста при
помощи линейки измеряли диаметр колоний в двух взаимноперпендикулярных
направлениях. За диаметр отдельной колонии в данный момент времени принимали
среднее арифметическое значение. Результаты измерений изображают графически в
равномерной или логарифмической шкале. Линейный рост определяют при изучении
влияния температуры, ингибиторов и т. п. при росте гриба на благоприятной среде
[Гарибова, 2005, с.41].
Вычисление радиальной скорости проводили по
формуле:
= (r - ro) / (t - to),
где k - радиальная скорость роста;- радиус
колоний в начальной момент времени to;- радиус колоний в момент времени t.
3. Результаты исследований
.1 Видовой состав
грибов рода Alternariа, поражающих подсолнечник в Краснодарском крае и симптомы
поражения растений разными видами
Для определения видового состава грибов рода
Alternaria,поражающих подсолнечник, из пораженных надземных органов растений,
собранных с экспериментального поля ВНИИМК за период вегетации 2012 года,
выделено 79 изолятов гриба. Из них специализированных крупноспоровых видов: A.
helianthi - 64, мелкоспоровые - 15 (приложение 1).
Получение чистых культур микромицетов осложнялось
присутствием других грибов A. tenuissima, A. infectoria, а также бактерий..
helianthi выделялся из разнообразных пятен на листьях, стеблях и корзинках
подсолнечника. Из пятен округлых от желтых до коричнево-черных с окаймлением
или без (в дальнейшем пораженные участки обычно выпадали, оставляя округлые
дыры) - на листьях (рис. 8a), а также на стеблях и корзинках (позже пятна могли
сливаться, образуя сплошное черное пятно) (рис. 8b).Из пятен полосковидных от
черно-коричневых до черных - на стеблях и корзинке (рис. 8c) и от светло - до
темно-коричневых c язвами и разрывами тканей на стеблях, корзинках, черешках и
по жилкам листьев (рис. 8d). Несколько изолятов было получено с семядолей и с
листьев растений подсолнечника в фазе 2-3 пар настоящих листьев (таблица 1).
Потери урожая семян от темно-бурой пятнистости
оцениваются разными специалистами от 8 до 84%. У образовавшихся семян
масличность может быть ниже нормы на 2-52%, а масса 1000 семян на 50%.
Из угловатых желтых, темнеющих до
коричнево-бурых, коричнево-черных пятен разного размера на листьях и корзинках,
обычно в местах повреждений насекомыми или на растениях, пораженных другими
патогенами, самостоятельно или с другими грибами и бактериями выделялись
мелкоспоровые виды (рисунок 9).
Преобладал A. tenuissima, A. alternatа и A.
infectoria встречались реже.
Виды A. alternata и A. tenuissima намного более
токсигенны для растений, чем представители комплекса A. infectoria, т.е.
способны синтезировать микотоксины и загрязнять ими сельскохозяйственную продукцию,
делая ее опасной для человека и животных.Исследования содержания в зерне
пшеницы метаболитов, опасных для теплокровных, показало, что концентрация
токсинов зависит от преобладания того или иного вида Alternaria. Например, в
тех районах, где пшеница поражается преимущественно A. infectoria, микотоксины
в зерне были найдены лишь в очень малых концентрациях, а где доминирует A.
Alternata - в больших.
Известен ряд случаев, когда виды A. alternata
вызывали сильные массовые заболевания различных растений, в т.ч. пшеницы,
подсолнечника. Вероятно, такие заболевания связаны с определенным сочетанием
погодных эдафических и агротехнических факторов, снижающих иммунитет растений и
благоприятствуют развитию патогенов. Ущерб от таких эпифитотий может быть
значительным. Например, потери урожая от листовой пятнистости подсолнечника
колебались в пределах 15-79% (рисунок 9).
Для большинства видов комплекса A.infectoria
характерно полное или почти полное отсутствие токсикогенности и низкая
патогенность. У некоторых представителей этого комплекса обнаружен ряд
метаболитов, являющихся структурными аналогами микотоксинов, продуцируемых
другими грибами, однако токсические свойства этих веществ пока не исследованы.
Визуальные наблюдения, сделанные во время
анализа микобиоты семян злаков, говорят о том, что семена, зараженные разными
видами Alternaria, прорастают без внешних аномалий и симптомов заболеваний. А
проростки зараженных семян обычно по размерам не отличаются от здоровых. Таким
образом, не было обнаружено фактов, говорящих о возможно серьезном
хозяйственном значение изученных видов Alternaria как возбудителей болезней
зерновых культур на территории России. Наибольшую опасность представляет широко
распространенный в семенах злаков вид A. tenuissima, способный к синтезу метаболитов,
токсичных для человека и теплокровных животных [Ганнибал, 2007, с.82].

Рисунок 8 - Поражение листьев (a,b,d), стеблей
(b,c,d) и корзинок (b) подсолнечника патогеном Alternaria helianthi

Рисунок 9 - Поражение листьев (a) и корзинки (b)
подсолнечника мелкоспоровыми видами Alternaria
Таблица 1 - Пример описания визуального анализа
симптомов заболевания
|
Номер
пробы
|
Внешний
вид (описание пятен)
|
Диаметр
пятна (см)
|
|
1
|
2
|
3
|
|
5.1
|
Округлое,
черно-коричневое на стебле
|
1,2
|
|
5.2
|
Округлое,
черно-коричневое на листе
|
1
|
|
6
|
Округлое,
от коричнево-бурого до черного, центр выпавший, с окаймлением до 2 см на
стебле
|
0,9
|
|
7
|
Округлое,с
темно-коричневым окаймлением, середина выпавшая (о,6 мм) на листе
|
0,9
|
|
8
|
Округлое
пятно , d c окаймлением 1,2 на стебле
|
1,2
|
|
9
|
Темно-коричневый
центр, трещина по центру на листе
|
0,9
|
|
10
|
Пятно
с темно-коричневый центром, трещина по центру на листе
|
0,9
|
|
11
|
Темно-коричневый
центр, трещина по центру на листе
|
1,1
|
|
12.1
|
Темно-коричневый
центр, трещина по центру на листе
|
1,1
|
|
12.2
|
Темно-коричневый
центр, трещина по центру на листе
|
1,1
|
|
13
|
Темное
окаймление, d окаймления хлороза 0,8 на стебле
|
0,3
|
|
14.1
|
Округлое,
центр светло-коричневый d 0,5 на листе
|
0,7
|
|
14.2
|
Черное
окаймление от 0,9 до 1 , черные штрихи по центральной жилке от 0,5 до 0,8 на
листе
|
1
|
|
15
|
Пятно
с светло-коричневым центром и темным окаймлением на листе
|
0,2
- 0,4
|
|
16
|
Штрих
с язвой до 0,8 на жилке
|
0.8
|
|
16.2
|
Штрих
до 0,4 на жилке
|
|
|
17.1
|
Пятно
округлое коричнево-черное на стебле
|
0,9
|
|
17.2
|
Пятно
угловатое, коричнево - черное на листе
|
1
|
|
18
|
Пятно
черно-коричневое, угловатое на листе
|
1,5-2
|
|
19
|
Пятно
с светло-коричневым центром на листе
|
0,2-0,4
|
|
20
|
Пятно
с светло-коричневым центром на листе
|
1,1,2
|
|
21
|
Пятно
серо-коричневое по краю округлое на листе
|
До
1,4
|
|
22
|
Черно-коричневое
пятно, округлое
|
До
1,5
|
|
23
|
Округлое
пятно , по центру, рядом с жилкой на листе
|
До
1
|
|
24
|
Округлое
пятно с окаймлением на листе
|
0,6-0,7
|
|
25
|
Округлое
пятно с окаймлением до 0,3-0,4 на листе
|
0,4-0,5
|
3.2 Видовой состав
грибов рода Alternariа, выделенных из семян подсолнечника
Семенами передается свыше 60% возбудителей
опасных болезней сельскохозяйственных культур. При сильном поражении семена
становятся невсхожими и теряют свое значение, как семенной материал, а при
слабом - снижается энергия прорастания, задерживается появление всходов и
развитие растений, посевы становятся изреженными, растения ослабленными, в
связи, с чем резко уменьшается не только урожай, но и снижается его качество.
Семена подсолнечника являются благоприятным
субстратом для развития патогенов и одним из главных источников его
распространения [Мурадасилова, 2006, с.52].
В результате анализа 8 партий семян
подсолнечника урожая 2012 года из нескольких регионов Краснодарского края получено
258 моноконидиальных изолятов грибов рода Alternaria и других темноокрашенных
гифомицетов (таблица 2).. tenuissima присутствовал в каждом образце и
доминировал в большинстве из них. Стабильно выявлялись A. infectoria и A.
alternata. Несколько изолятов отнесено к A. arborescens и к другим родам
альтернариоидных гифомицетов - Stemphylium и Ulocladium. В семенах из
Славянского и Белоглинского районов Краснодарского края обнаружено по одному
изоляту A. helianthi. При выделении грибов из семян подсолнечника в чистую
культуру отмечены случаи ассоциаций разных видов Alternaria друг с другом и
иной микобиотой - преимущественно с Rhizopussp., Fusariumsp.,
Penicilliumsp.,Stemphyliumsp. и с бактериями (рисунок 18,19).
В ходе данного исследования некоторые изоляты не
удалось определить по морфологическим признакам до вида. Для их идентификации
необходимо применение молекулярно-генетических методов.
Таблица 2 - Инфицированность грибами рода
Alternaria и другими темноокрашенными гифомицетами образцов семян подсолнечника
из нескольких районов Краснодарского края
|
№
|
Район
сбора
|
Генотип
хозяина
|
Инфицированность
образца, %
|
Изоляты,
шт.
|
|
|
|
|
всего
|
A.
tenuissima
|
комплекс
A. infectoria
|
A.
alternata
|
Другие
|
|
1
|
Кореновский
|
ВД
541А
|
4
|
6
|
4
|
2
|
-
|
-
|
|
2
|
|
ВК
653
|
16
|
14
|
9
|
1
|
4
|
-
|
|
3
|
г.
Краснодар
|
неизвестен
|
46
|
32
|
13
|
13
|
4
|
A.
arborescens-2
|
|
4
|
|
|
58
|
40
|
22
|
12
|
6
|
-
|
|
5
|
|
неизвестен
|
58
|
48
|
30
|
12
|
3
|
Alternaria
sp.-1, Stemphylium sp.- 1, Ulocladium sp.- 1
|
|
6
|
Славянский
|
ВК-680
|
22
|
16
|
12
|
2
|
1
|
A.
helianthi -1
|
|
7
|
Белоглинский
|
неизвестен
|
19
|
19
|
11
|
3
|
2
|
A.
helianthi -1, Alternaria sp. -2
|
|
8
|
Крыловской
|
неизвестен
|
35
|
30
|
23
|
2
|
3
|
Alternaria
sp. -1, Stemphylium sp. - 1
|
В совокупности, среди выделенных из семян
подсолнечника темноокрашенных гифомицетов преобладали мелкоспоровые виды
Alternaria: A. tenuissima - 61 %, комплекса A. infectoria - 23 % и A. alternata
- 11% (рисунок 17).
Полученные в ходе работы данные во многом
согласуются с представленными Ф. Б. Ганнибалом и дополняют их обнаружением в
семенах подсолнечника B. australiensis и A. helianthi. Видовой состав грибов
рода Alternaria на подсолнечнике разнороден: значительны различия между видами
по степени специализации, токсигенности, патогенности, вредоносности,
чувствительности к фунгицидам и многим другим характеристикам. Это обязывает
начинать любые исследования, связанные с альтернариозом подсолнечника, с
видовой идентификации патогена.
Таким образом, в настоящее время на
подсолнечнике в Краснодарском крае, областях встречаются различающиеся по
экологическим особенностям виды Alternaria. Из них специализированные
крупноспоровые - A.helianthi, A. helianthiinficiens и A. protenta;
мелкоспоровые неспециализированные - A. tenuissima, A. alternata, A.
arborescens и комплекса A. infectoria,а также родственные им stemphylium sp.и ulocladium
sp. (рисунок 20).

Рисунок 11 - Изолят гриба в чашке Петри [Фото
автора, 2012]

Рисунок 12 - A. helianti и мелкоспоровый вид
Alternaria [Фото автора, 2012]
Рисунок 13 - Растения подсолнечника, выросшие из
семян с зародышами, поражёнными грибами мелкоспоровых видов Alternaria
spp.[Фото Ивебор М.В., 2012]
3.3
Влияние температуры и освещенности на морфолого-культуральные свойства
нескольких видов грибов рода Alternariа, выделенных из растений и семян
подсолнечника
Мы изучали влияние температуры и освещенности на
радиальный и линейный рост штаммов.
Особенности роста колоний микроскопических
грибов, как правило, изучают на твердых питательных средах. В таких колониях
мицелий развивается из споры, при прорастании которой образуется одна или
несколько ростовых трубок. Ростовые трубки удлиняются, отделяются от споры
перегородкой, затем происходит развитие системы ветвящихся гиф, имеющих
верхушечный (апикальный) рост и боковое (латеральное) ветвление. В отсутствии
препятствий гифы растут центробежно от центра колонии, в результате чего
формируется грибная колония сферической формы. Дальнейший рост колонии
происходит за счет периферической зоны. Позднее в центральной более старой
части колонии формируются репродуктивные структуры. В центре колонии начинается
лизис мицелия и колония стареет. Для определенных видов грибов характерны свои
скорости роста, вытягивания и ветвления гиф, потребления субстрата, накопления
продуктов обмена и старения мицелия, что в конечном итоге определяет облик
развивающихся на твердых средах колоний микроскопических грибов (рисунок 21)
[Паников, 1991, с.45].
Лаг-фаза - первая стадия развития грибной
колонии. Эта фаза определяется нахождением спор грибов в состоянии покоя.
Различают два типа покоя спор: конститутивный и экзогенный.

Рисунок 14 - Изолят № 2 (A. helianthi) на 12
сутки (А - свет, В - темнота)
Конститутивный покой поддерживается благодаря
свойствам, присущим самим спорам: морфологическим особенностям спор - созданию
за счет строения клеточной стенки и формы эндоплазматического ретикулума -
естественных барьеров для проникновения кислорода, воды, питательных веществ,
метаболитов внутрь споры, благодаря химическому составу содержимого спор,
например, низкому содержанию воды, но высоким концентрациям таких веществ как
карбогидраты, фосфолипиды, жирные кислоты, спирты, свободные аминокислоты и
др., а также за счет замедленной метаболической активности, например, из-за
дефицита ферментов, входящих в электронно-транспортную цепь митохондрий,
присутствию самоингибиторов прорастания спор и т.д..
Экзогенный покой определяется присутствием
неблагоприятных для прорастания спор химических и физических факторов
окружающей среды, например, уровней влажности, питательных веществ, кислорода,
углекислоты, температуры, освещения, высоких доз загрязнителей,
антагонистического воздействия других микроорганизмов, выделения самоингибиторов
роста и т.д.. Основное различие между конститутивно и экзогенно покоящимися
спорами грибов проявляется в необходимости специальной активации для инициации
прорастания первых, в то время как для вторых достаточно поместить споры в
благоприятные для роста данного вида гриба условия среды. Обычно это наличие
определенного уровня влажности, температуры, содержания питательных веществ, в
первую очередь, сахаров и аминокислот, а также кислорода и т.д.
Стимуляторами прорастания конститутивно
покоящихся спор может быть воздействие высоких или низких температур, обработка
химическими реагентами, внесение питательных веществ, низких концентраций
тяжелых металлов, воздействие света и т.д. Стимулирование прорастания спор
одних грибов может наблюдаться в присутствии покоящихся структур других видов.
Предполагают, что многие вещества, стимулирующие прорастание спор грибов,
действуют как катализаторы, либо инактивируют имеющиеся в споре естественные
ингибиторы. Иногда споры прорастают в результате аутоактивации веществами,
продуцируемыми самими спорами с возрастом или при высокой плотности споровой
суспензии. Так что длительность лаг-фазы определяется не только составом
питательной среды, но также количеством и возрастом посевного материала.
При активации спор грибов происходят
множественные биохимические, цитологические и морфологические изменения:
нарушается проницаемость клеточной стенки спор, начинают активно поступать
внутрь вода, питательные вещества, возрастает содержание продуктов обмена.
Спора набухает, увеличивается в размерах, идет активный синтез аминокислот,
белков, компонентов цитоплазмы и клеточной стенки грибов. Намечается полярный
центр роста и из споры развивается ростовая трубка.
Дальше начинается стадия развития мицелия -
наиболее функционально значимая стадия жизненного цикла грибов в наземных
экосистемах, особенно в почвах. Ростковая трубка, развивающаяся из споры,
растет преимущественно за счет ее внутренних резервов.
Далее следует фаза экспоненциального роста
гриба, в которой грибная микроколония находится в условиях сбалансированного
роста: все необходимые питательные вещества пока еще присутствуют в достаточных
количествах, развитие грибной колонии не тормозится ингибирующими продуктами
обмена веществ.
Рост колоний грибов происходит за счет удлинения
гиф и ветвления мицелия. Число клеток в гифах при этом возрастает за счет
деления апикальных клеток. Гифы в краевой зоне колонии распространяются с
постоянной линейной скоростью удлинения. При этом нарастание общей длины
мицелия и биомассы в колонии продолжает происходить экспоненциально с
постоянной скоростью (μmax) за
счет экспоненциального образования новых ветвей.
Экспоненциальное увеличение длины гиф не может
продолжаться не-ограничено долго, в дальнейшем происходит исчерпание
питательных веществ, накопление токсичных метаболитов и развитие гриба
переходит в фазу замедления роста. Эта фаза - сравнительно длительна и является
одной из основных в жизненном цикле грибов. Большую часть этой фазы гриб растет
с линейной скоростью. В процессе линейного роста обычно достигается наибольший
суммарный прирост длины мицелия, общей биомассы грибной колонии. Для описания
линейного роста часто используют показатель радиальной скорости роста (Kr),
который определяется как увеличение диаметра колоний за определенный промежуток
времени. В фазе стационарного роста колония растет за счет своей периферической
зоны, ширина которой (w) остается определенное время постоянной. Радиальная
скорость роста определяется через рост в периферической зоне и связана с
удельной скоростью роста: Kr=μw.
Скорость радиального роста у разных видов грибов
отличается, но сравнительно постоянна для конкретных видов. Она остается
таковой довольно длительный период в определенных экологических условиях
(например, при определенной концентрации и качестве питательных веществ,
температуре, влажности, pH и т.д.), но может меняться при их изменении.
Хотя абсолютный прирост общей длины мицелия в
колонии в этой фазе еще может быть велик, но в дальнейшем радиальная скорость
роста мицелия начинает уменьшаться. Это вызвано изменениями условий среды -
исчерпанием питательных ресурсов, накоплением продуктов жизнедеятельности
гриба, изменением кислотности среды в процессе роста, нарушением кислородного
баланса, накоплением АФК, ограничением пространства и т.д.
При первоначальном, активном развитии мицелия
происходит процесс формирования грибных колоний и его важнейшим элементом
является образование ветвей. При развитии колонии от основных «родительских»
гиф формируются ветви 1-го, 2-го, 3-го и т.д. порядков. Их ориентация и
морфологические характеристики могут определяться стадией развития гриба и
факторами среды. В экспоненциальной фазе роста ветви последующих порядков
формируются перпендикулярно «родительским» гифам. В дальнейшем из-за уменьшения
субстрата и свободного пространства углы наклона гиф уменьшаются, соотношение
диаметров основных и гиф других порядков может меняться.
Грибная колония развивается как целостный
организм и ветвление происходит сбалансировано.
Инициация ветвления связана с механизмами,
регулирующими толщину и скорость вытягивания гиф, удельную скорость роста гриба
в определенных условиях среды.
У некоторых грибов четко прослеживается связь
между образованием ветвей и образованием септ в мицелии. Как правило, ветви
располагаются непосредственно перед септой. У некоторых септированных видов
грибов установлен приблизительно одинаковый интервал времени между появлением
клеточных перегородок и ветвей. В то же время показано, что инициация ветвления
и септообразование в грибных гифах определяются количеством ядер в апикальных и
интеркаларных клетках.
Направление вытягивания основных гиф и их
ответвлений определяется факторами среды. Грибные гифы распространяются из
областей, где условия ухудшились: истощился запас питательных веществ, возросло
содержание вторичных метаболитов гриба, появился дефицит кислорода - в области
с достаточным количеством питания, содержания кислорода, вне зоны продуктов
обмена и т.д. При дискретном распределении субстрата в среде грибные гифы
первоначально распространяются в поисках источника питания, в разные стороны, а
при обнаружении растут в его направлении.
Показан и ряд иных факторов, влияющих на
направление вытягивания гиф. Например, гелиотропизм, или наличие регуляторных
веществ, продуцируемых самим грибом, которые диффундируют в окружающую среду и
направляют рост гиф от себя. Продемонстрировано значение содержания влаги для
развития грибных колоний, а именно, зависимость направления роста гиф в краевой
зоне колоний от активности воды. Одним из важнейших механизмов, регулирующих на
клеточном уровне направление и скорости вытягивания гиф, является
внутриклеточный градиент ионов Ca2+.
В фазе замедления роста в колонии начинают
образовываться бесполые и половые спороношения. Начало этого процесса связывают
с исчерпанием субстрата, дефицитом кислорода, накоплением вторичных метаболитов
продуктов под более старыми частями колонии и т.д. Одновременно часто имеет
место автолиз гиф, отмирание клеток, то есть начинается старение колонии. В
этот период развития в колонии одновременно выделяются зоны (от центральной
части к периферии), в которых грибной мицелий находится в разных фазах роста,
то есть колония приобретает черты «круговой» морфологии.
Далее наступает относительно кратковременная
стационарная фаза роста гриба. В этот период активный рост прекращается, хотя
грибная колония остается метаболически активной. Скорости роста мицелия в
краевой зоне колонии компенсируются скоростями отмирания, лизиса клеток в
центре колонии. Во внутренних зонах мицелий перестает вытягиваться, нарушается
направленность роста гиф.
После стационарной фазы наступает фаза отмирания
колонии. В колонии усиливаются процессы отмирания клеток, автолиза, и в
результате биомасса колонии уменьшается. Закономерности процессов, протекающих
в этой завершающей стадии старения колонии, до сих пор изучены в наименьшей
степени.
Продолжительность каждой фазы жизненного цикла
грибов определяется как их видовой специфичностью, так и экологическими
факторами среды.
При изменении условий среды могут наблюдаться не
только изменения длительности отдельных стадий, но и нарушение их
последовательности, например, как бы «выпадение» отдельных стадий. Один из
примеров этого - важное для почвенных процессов явление микроциклического
развития, при котором мицелиальные стадии развития - не выражены, и развитие
спороношений происходит на ростковых трубках. Как правило, это явление
характерно для стрессовых изменений условий среды - температурных и питательных
шоков [Гарибова, 2005, с.105].
Достаточное количество тепла - одно из основных
условий жизни гриба. Причем активная жизнедеятельность каждого вида возможна в
пределах определенных температурных границ. Наиболее гармоничное течение
обменных процессов наблюдается при температурном оптимуме. Воздействие слишком
низких или слишком высоких температур приводит к глубоким нарушениям в
координации процессов жизнедеятельности, к необратимым повреждениям цитоплазмы.
Если температура снижается и переходит в критическую, прекращается движение
цитоплазмы, утрачивается полупроницаемость мембран и клетка гибнет. Высокая
температура также приводит к гибели клетки вследствие "нарушения мембран,
наступающего в результате инактивации и денатурации белков и расстройства
обменных процессов.
Солнечная радиация оказывает существенное
воздействие на процессы жизнедеятельности грибов, хотя действие разных участков
спектра солнечного излучения неодинаково. Большинство грибов растет с примерно
одинаковой интенсивностью на свету и в темноте [Паников, 1991, с.87].

Рисунок 15- Влияние температуры и освещенности
на линейный рост колонии A. helianthi (1-й штамм)
Определение влияния температуры и освещенности
на линейный рост колонии A. helianthi (рисунок 15) показало, что самый быстрый
рост колоний происходил при освещении и температуре +28°С, самый медленный - в
темноте и температуре 15,5°С. Диаметр равный 9 см был достигнут на 14-е сутки
при освещении и температуре +28°С. Колонии гриба в темноте и t°
- +15,5°С росли медленно, особенно с 7-х суток. При освещении и t°
- +15,5°С с первых суток наблюдается плавный рост конидий, но диаметр равный 9
см не был достигнут и на 34-е сутки.

Рисунок 16 - Влияние температуры и освещенности
на линейный рост колонии A. helianthi (2-й штамм)
Определяя влияние температуры и освещенности на
линейный рост колонии 2 штамма (рисунок 16), мы видим, что колонии гриба
находившиеся на свету и t° - +28°С, растут активно и достигают
диаметра 9 см на 17-е сутки. Самый медленный рост у колоний, находившихся в
темноте и t° - +15,5°С, рост продолжался до 9-х суток, а
потом прекратился. Колонии гриба при свете и t° - +15,5°С
росли равномерно.
Исследуя влияние температуры и освещенности на
линейный рост колоний 3 штамма (рисунок 17), мы видим при всех условиях
активный рост. Однако, при свете и t° - +28°С диаметр 9
см был достигнут на 11-е сутки, в сравнении с ростом колонии в темноте и t°
- +28°С на 16-е сутки, при свете и t° - +15,5°С на 17-е
сутки и в темноте и t°- +15,5°С на 18-е сутки.

Рисунок 17 - Влияние температуры и освещенности
на линейный рост колонии A. tenuissima (3-й штамм)

Рисунок 18- Радиальная скорость роста колоний
штамма 1 (A. helianthi) в зависимости от температуры и освещенности
Определяя скорость радиального роста колоний
штамма 1 мы обнаружили, что самая активная скорость наблюдалась при
освещенности и t° - +28°С, самая медленная в темноте
и t°
- +15,5°С (рисунок 18). В темноте и t° - +28°С с 1-х по
4-е сутки наблюдался активный рост, а в дальнейшем спад активности. При свете и
t°
- +15,5°С радиальная скорость роста была средней.

Рисунок 19 - Радиальная скорость роста колоний
штамма 2 (A. helianthi) в зависимости от температуры и освещенности
Радиальная скорость роста колоний штамма 2
(рисунок 19) при освещенности и t° - +28°С была самой
быстрой, самая медленная скорость наблюдалась при темноте +15,5°С, на 10-е
сутки скорость остановилась на отметке 1,89 мм/сут. При условиях света и t°
- +15,5°С скорость увеличивалась плавно. Скорость колоний гриба при условиях
темноты и t° - + 28°С на 3-е сутки увеличивалась равномерно,
с 14-х суток скорость оставалась практически неизменной.
Исследование радиальной скорости штамма 3 (A.
tenuissima) показывает (рисунок 20), что при всех температурных и световых
условиях скорость увеличивалась равномерно. Самый быстрый радиальный рост
колоний наблюдался при свете и t°- +28°С, в темноте
и t°-
+15,5°С радиальный рост был наименее активен, чем при других условиях.

Рисунок 20 - Радиальная скорость роста штамма 3
(A. tenuissima) в зависимости от температуры и освещенности
Из рисунка 21 следует, что при температурных и
световых условиях : свет и t° - +28°С, линейный рост всех
трех штаммов происходил активно, однако колонии 3 штамма росли быстрее и
достигли диаметра 9 см на 11-е сутки, при тех же условиях колонии 1 штамма
достигли 9 см на 14-е сутки, колонии штамма 2 только на 17-е сутки выросли до 9
см.
В темноте и t° - + 28°С (рисунок
22) самый активный линейный рост колоний наблюдался у 3 штамма, с 2-х суток
рост быстро увеличивался и достиг 9 см в диаметре на 16-е сутки, у 2 и 3 штамма
линейный рост был почти одинаков и достиг 9 см в диаметре на 18-е сутки.
Исследуя линейный рост при условиях света и t°
- 15, 5°С (рисунок 23) мы видим, что самый быстрый рост колоний наблюдался у 3
штамма, с 5-х суток развитие шло наиболее активно. Рост колоний 1 и 2 штаммов
происходил практически одинаково, диаметра 9 см они достигли на 18-е сутки.


Исследуя линейный рост при условиях темноты 15,
5°С (рисунок 24) мы видим, что самый быстрый рост колоний наблюдался у 3
штамма, с 3-х суток развитие шло наиболее активно. Рост колоний 1 и 2 штамма
происходит практически одинаково, однако у 2 штамма рост был немного быстрее.
Так же все три штамма достигли диаметра 9 см на 18-е сутки.
При низких температурах у всех исследованных
видов грибов (Alternaria alternata, A. tenuissima) было отмечено значительное
снижение способности к росту. Максимальная способность к росту отмечалась при
+28°С. У 1 и 2 штаммов и в условиях освещенности и в условиях темноты конидии
формировались активно, у штамма 3 конидии активно формировались только в условиях
освещенности, а в условиях темноты их было значительно меньше.
Изоляты A. helianti могут отличаться друг от
друга своей адаптационной способностью. Скорость роста и развития A. tenuissima
превышает развитие A. helianthi , эта способность наблюдается и в природе. При
визуальном осмотре образца иногда развитие A. tenuissima настолько сильно, что
сложно найти A. helianti. Обильный рост A. tenuissima усложняет ситуацию и её
токсикогенные свойства увеличиваются.
ЗАКЛЮЧЕНИЕ
Род Alternaria Nees представлен более чем 250
разнообразными видами, многие из которых - космополиты, встречающиеся
практически повсеместно. Они относятся к микроскопическим грибам, с которыми
человек сталкивается наиболее часто. Целый ряд видов Alternaria вызывает
вредоносные болезни сельскохозяйственных культур, в том числе подсолнечника.
Потери урожая от A.helianti оцениваются разными
специалистами от 8 до 84%, у образовавшихся семян масличность может быть ниже
нормы на 2-52%.
Среди выделенных мелкоспоровых наиболее токсичны
A.alternata и A.tenuissima. A.tenuissima способен к синтезу метаболитов,
токсичных для человека и теплокровных животных. Известны случаи, когда виды
A.alternata вызывали сильные массовые заболевания различных растений.
Для большинства видов комплекса A.infectoria
характерно полное или почти полное отсутствие токсикогенности и низкая
патогенность.
Основная проблема заключается в недостаточной
изученности самого патогена. Видовой состав грибов рода Alternaria, заселяющих
растения и семена подсолнечника, изучен мало.
Изучение видового состава и условий
произрастания видов необходимо для:
разработок мер борьбы с альтернариозом:
определения необходимых мероприятий по
профилактике;
селекционной работы;
выявления влияния альтернариозов на семена
подсолнечника и изменения пищевой ценности конечного продукта;
определения влияния на организм человека, как
токсинов самого гриба, так и его метаболитов.
В результате проведенной работы мы определили,
что на растениях и семенах подсолнечника в районах Краснодарского края
встречаются следующие виды грибов рода Alternaria:
специализированные крупноспоровые A.helianthi,
A. helianthiinficiens и A. protenta;
мелкоспоровые неспециализированные A.
tenuissima, A. alternata, A. arborescens и комплекса A. infectoria,а также
родственные им Stemphylium sp.и Ulocladium sp.
Из них наиболее токсигенные и патогенные виды A.
alternata и A. tenuissima.
При определении влияния температуры и
освещенности на рост грибов, установлено, что оптимальные условия для роста
колоний - температура воздуха +28°С и наличие света.
СПИСОК ИСПОЛЬЗУЕМЫХ ИСТОЧНИКОВ
Бородин
С.Г. Селекция и семеноводство сортов-популяций подсолнечника. М.:
Агропромиздат, 2002. 283 с.
Билай
В.И. Основные микологические методы в фитопатологии. Киев: Наукова думка, 1982,
С.341
Великанов
Л. Л. Некоторые биохимические аспекты в экологии грибов. М.: Агропромиздат,
2002. С. 210
Володичев
М.А. Защита зерновых культур от вредителей. М.: Росагропромиздат, 1990. С.93
Воронин
К.Е. Биологическая защита зерновых культур от вредителей. М.: Агропромиздат,
1998. С.57
Васильев
Д.С. Подсолнечник. М.: Агропромиздат, 1990 254 с.
Ганнибал,
Ф. Б. Видовой состав, систематика и география возбудителей альтернариозов
подсолнечника в России // Вестник защиты растений. 2011. №1. С. 13-19
Ганнибал
Ф. Б. Альтернариозы сельскохозяйственных культур на территории России // Защита
и карантин растений, 2010. № 5. С. 30-32.
Ганнибал
Ф.Б. Мелкоспоровые виды рода Alternaria на злаках// Микология и фитопатология.
2004. № 3. С.19
Ганнибал
Ф.Б. Alternaria spp. В семенах зерновых культур в России// Микология и
фитопатология. 2008. № 4. С. 35
Ганнибал
Ф.Б. Токсигенность и патогенность грибов рода Alternaria для злаков. СПб.:
ВИЗР, 2007. С.82
Ганнибал
Ф.Б. Альтернариозы сельскохозяйственных культур на территории России// Защита и
карантин растений, 2010, №5 С.30
Гарибова
Л. В. Основы микологии: Морфология и систематика грибов и грибоподобных
организмов. М.: Товарищество научных изданий КМК, 2005, С.287
Гусева
О.Г. Экологические проблемы защиты растений. Л.: ВИЗР, 1990, С.113
Долженко
Е.Г. Биология гриба PHOMOPSIS HELIANTI и меры борьбы с ними в условиях
Краснодарского края. Краснодар, 2000. 143 с.
Дьяков
А.Б. Физиология подсолнечника. Краснодар, 2004. С.73
Заболотный
Д.К. Микроорганизмы - возбудители болезней растений. Киев: Наук. Думна, 1988.
С. 36
Лукомец
В. M. Болезни подсолнечника. М.: Агрорус, 2011. 210 с.
Мурадасилова
Н.В. Симптомы поражения главного корня проростков и растений подсолнечника
грибами рода Alternaria// Науч.-техн. Бюл. ВНИИМК. Краснодар, 2000, № 12 С.
32-34
Никитин
Д.П. Окружающая среда и человек. М.: АСТ, 2007. С. 43-44
Никитичин
Д.И. Гибридный подсолнечник. Киев: Урожай, 1989. С.65
Калайджян
А.А. Подсолнечник и его изменчивость. М.: Агропроиздат, 2003. С. 43
Коваль
Э.З. Микроскопическое изучение грибов. Киев: Наукова думка, 1982, С. 340
Коробкин
В.И. Экология. М.: Феникс, 2010. С. 51-54
Мурадасилова
Н. В. Симптомы поражения альтернариозом центрального корня проростка
подсолнечника // Защита и карантин растений, 2006, № 2. C. 52-53.
Паников
Н. С. Кинетика роста микроорганизмов. М.: Наука, 1991. С.304
Пидопличко
Н.М. Грибы-паразиты культурных растений. Киев: Наукова думка, 1977. С. 201
Пикалова
Н.А. Фенотипическая изменчивость кислотного числа масла в семенах
подсолнечника. Краснодар, 2009. С.32
Пустовойт
В.С. Подсолнечник. М.: Колос,1975. С.71
Санин
С.С. Фитосанитарная экспертиза зерновых культур. М.: Росинформагротех, 2002. С.
140
Семенов
А.Я. Диагностика грибных болезней семян хлебных и крупяных знаков. М.:
Агропромиздат, 1979, С.42
Тихонов
О.И. Болезни подсолнечника. Краснодар: ВНИИМК, 1988. С. 44
Тютерев
С.Л. Биохимические методы исследования болезнеустойчивости растений. СПб.:
ВИЗР, 2001, С. 67
Якуба,
Г. В. Эволюция паразитических свойств Alternaria alternata на яблоне в условиях
Краснодарского края // Плодоводство и ягодоводство России. М, 2010. № 3. С.
380-386.A. A. Light and Scanning Electron Microscopy Studies on the Penetration
and Infection Processes of Alternariaalternata, Causing Brown Spot on Minneola
Tangelo in the West Mazandaran - Iran // World Applied Sciences Journal ,
2007.Vol. 2. pp. 68-72.T. Effect of relative humidity on oil properties of
fungal infested sunflower seeds. // Biological Bulletin, 2011.Vol. 5. рp.
85-86Vikas V. Symptomatological Studies on Leaf Blight of Sunflower Caused by
Alternariahelianthi in Rohilkhand.// Advances in bioresearches, 2010. Vol. 1.
pp. 97H. S. Three Alternaria Species Pathogenic to Sunflower. // Plant Pathol,
J., 2011. Vol. 16. p. 338E. G. Alternaria. An Identification Manual. Utrecht:
CBS, 2007. 775 p.
Приложение 1

Рисунок 25 - Листья с альтернариозом [Фото
автора, 2012]

Рисунок 26 - Измерение пятна альтернариоза [Фото
автора, 2012]

Рисунок 27 - Описание и нумерация изолятов гриба
[Фото автора, 2012]

Рисунок 28 - Изолят гриба в чашке Петри [Фото
автора, 2012]
Рисунок 29 - Изолят гриба через 7 дней [Фото
автора, 2012]

Рисунок 30 - Грибы рода Alternaria под
микроскопом [Фото автора, 2012]

Рисунок 31 - Конидия A.helianthi [Фото автора,
2012]
Приложение 2
Таблица 3 - Линейный рост колоний штамма 1 ((A.
helianthi)
|
сутки
|
свет,
+28°С
|
темнота,
+28°С
|
свет,
+15,5°С
|
темнота,
+15,5°С
|
|
1
|
0,2
|
0,2
|
0,15
|
0,15
|
|
2
|
0,5
|
0,7
|
0,3
|
0,2
|
|
3
|
1
|
1,275
|
0,4
|
0,3
|
|
4
|
1,55
|
1,8
|
0,8
|
0,75
|
|
5
|
2,05
|
2,1
|
0,95
|
0,75
|
|
6
|
2,6
|
2,4
|
1,3
|
1,075
|
|
7
|
3,45
|
2,9
|
1,5
|
1,2
|
|
8
|
4,4
|
3,475
|
1,7
|
1,3
|
|
9
|
5,7
|
3,75
|
1,9
|
1,4
|
|
10
|
6,5
|
3,9
|
2,1
|
1,5
|
|
11
|
7,1
|
4,125
|
2,45
|
1,515
|
|
12
|
7,8
|
4,3
|
2,8
|
1,575
|
|
13
|
8,5
|
4,5
|
3,2
|
1,61
|
|
14
|
9
|
4,8
|
3,35
|
1,62
|
|
15
|
|
5,05
|
3,475
|
1,625
|
|
16
|
|
5,1
|
3,6
|
1,63
|
|
17
|
|
5,15
|
3,61
|
1,65
|
Таблица 4 - Линейный рост колоний штамма 2 (A.
helianthi)
|
сутки
|
свет,
+28°С
|
темнота,
+28°С
|
свет,
+15,5°С
|
темнота,
+15,5°С
|
|
|
|
|
|
|
1
|
0,2
|
0,2
|
0,15
|
0,15
|
|
2
|
0,5
|
0,6
|
0,2
|
0,2
|
|
3
|
0,975
|
1,25
|
0,4
|
0,3
|
|
4
|
1,725
|
1,9
|
0,75
|
0,55
|
|
5
|
2
|
2,375
|
0,85
|
0,8
|
|
6
|
2,65
|
2,75
|
1,2
|
1,2
|
|
7
|
3,1
|
3,3
|
1,4
|
1,5
|
|
8
|
3,8
|
3,75
|
1,65
|
1,8
|
|
9
|
5
|
4,5
|
2,1
|
1,9
|
|
10
|
5,6
|
4,85
|
2,3
|
1,9
|
|
11
|
6,1
|
5,15
|
2,65
|
1,9
|
|
12
|
6,7
|
5,4
|
3
|
1,9
|
|
13
|
7,25
|
5,45
|
3,3
|
1,9
|
|
14
|
8
|
5,5
|
3,55
|
1,9
|
|
15
|
8,5
|
5,505
|
4
|
1,9
|
|
16
|
9
|
5,51
|
4,15
|
1,91
|
|
17
|
0,2
|
0,2
|
0,15
|
0,15
|
Таблица 5 - Линейный рост колоний штамма 3 ((A.
tenuissima)
|
сутки
|
свет,
+28°С
|
темнота,
+28°С
|
свет,
+15,5°С
|
темнота,
+15,5°С
|
|
1
|
0,3
|
0,3
|
0,1
|
0,2
|
|
2
|
0,95
|
0,7
|
0,35
|
0,3
|
|
3
|
2,6
|
1,9
|
0,6
|
0,4
|
|
4
|
3,3
|
2,9
|
1,55
|
1,4
|
|
5
|
4,3
|
3,95
|
2
|
1,8
|
|
6
|
5,6
|
4,6
|
2,95
|
2,75
|
|
7
|
6,5
|
5,4
|
3,7
|
3,325
|
|
8
|
7,5
|
6,1
|
4,4
|
3,9
|
|
9
|
7
|
5,3
|
4,75
|
|
10
|
8,5
|
7,5
|
6
|
5,5
|
|
11
|
9
|
7,8
|
6,5
|
6
|
|
12
|
6,1
|
8,1
|
7
|
6,4
|
|
13
|
6,7
|
8,4
|
7,4
|
6,9
|
|
14
|
7,25
|
8,6
|
7,7
|
7,3
|
|
15
|
8
|
8,8
|
8,1
|
7,6
|
|
16
|
8,5
|
9
|
8,6
|
8,05
|
|
17
|
9
|
5,51
|
9
|
8,5
|
Таблица 6 - Радиальный колоний штамма 1 (A.
helianthi)
|
сутки
|
свет,
+28°С
|
темнота,
+28°С
|
свет,
+15,5°С
|
темнота,
+15,5°С
|
|
1
|
0,1
|
0,1
|
0,05
|
0,05
|
|
2
|
0,2
|
0,3
|
0,1
|
0,05
|
|
3
|
0,3
|
0,39
|
0,1
|
0,07
|
|
4
|
0,3625
|
0,425
|
0,175
|
0,1625
|
|
5
|
0,39
|
0,4
|
0,24
|
0,13
|
|
6
|
0,42
|
0,383
|
0,2
|
0,1625
|
|
7
|
0,49
|
0,4
|
0,2
|
0,16
|
|
8
|
0,54
|
0,42
|
0,2
|
0,15
|
|
9
|
0,62
|
0,45
|
0,2
|
0,14
|
|
10
|
0,64
|
0,38
|
0,2
|
0,14
|
|
11
|
0,636
|
0,38
|
0,21
|
0,13
|
|
12
|
0,642
|
0,38
|
0,22
|
0,12
|
|
13
|
0,646
|
0,34
|
0,24
|
0,12
|
|
14
|
0,636
|
0,36
|
0,23
|
0,11
|
|
15
|
8
|
0,33
|
0,225
|
0,1
|
|
16
|
8,5
|
0,3125
|
0,22
|
0,095
|
|
17
|
9
|
0,3
|
0,21
|
0,09
|
Таблица 7 - Радиальный колоний штамма 2 (A.
helianthi)
|
сутки
|
свет,
+28°С
|
темнота,
+28°С
|
свет,
+15,5°С
|
темнота,
+15,5°С
|
|
1
|
0,1
|
0,1
|
0,7
|
0,7
|
|
2
|
0,05
|
0,25
|
0,05
|
0,05
|
|
3
|
0,26
|
0,38
|
0,1
|
0,06
|
|
4
|
1,6
|
1,8
|
0,7
|
0,52
|
|
5
|
1,98
|
2,35
|
0,8
|
0,8
|
|
6
|
2,63
|
2,73
|
1,18
|
1,18
|
|
7
|
3,08
|
3,28
|
1,38
|
1,48
|
|
8
|
3,78
|
3,73
|
1,63
|
1,78
|
|
9
|
4,99
|
4,49
|
2,09
|
1,89
|
|
10
|
5,59
|
4,84
|
2,29
|
1,89
|
|
11
|
6,09
|
5,14
|
2,64
|
1,89
|
|
12
|
6,69
|
5,39
|
2,99
|
1,89
|
|
13
|
7,24
|
5,44
|
3,29
|
1,89
|
|
14
|
7,99
|
5,49
|
3,54
|
1,89
|
|
15
|
8,49
|
5,49
|
3,99
|
1,89
|
|
16
|
8,99
|
5,5
|
4,14
|
1,9
|
|
17
|
0,1
|
0,1
|
0,7
|
0,7
|
Таблица 8 - Радиальный колоний штамма 3 (A.
tenuissima))
|
сутки
|
свет,
+28°С
|
темнота,
+28°С
|
свет,
+15,5°С
|
темнота,
+15,5°С
|
|
1
|
0,2
|
0,2
|
0
|
0,1
|
|
2
|
0,9
|
0,65
|
0,3
|
0,25
|
|
3
|
2,56
|
1,86
|
0,56
|
0,36
|
|
4
|
3,27
|
2,87
|
1,52
|
1,37
|
|
5
|
4,27
|
3,93
|
1,98
|
1,78
|
|
6
|
5,58
|
4,58
|
2,93
|
2,73
|
|
7
|
6,48
|
5,38
|
3,68
|
3,3
|
|
8
|
7,4
|
6,08
|
4,38
|
3,88
|
|
9
|
8,08
|
6,98
|
5,28
|
4,73
|
|
10
|
8,49
|
7,49
|
5,99
|
5,49
|
|
11
|
8,99
|
7,79
|
6,49
|
5,99
|
|
12
|
6,1
|
8,09
|
6,99
|
6,39
|
|
13
|
6,7
|
8,39
|
7,39
|
6,89
|
|
14
|
7,25
|
8,59
|
7,69
|
7,29
|
|
15
|
8
|
8,79
|
8,09
|
7,59
|
|
16
|
8,5
|
8,99
|
8,59
|
8,04
|
|
17
|
9
|
5,51
|
8,99
|
8,49
|